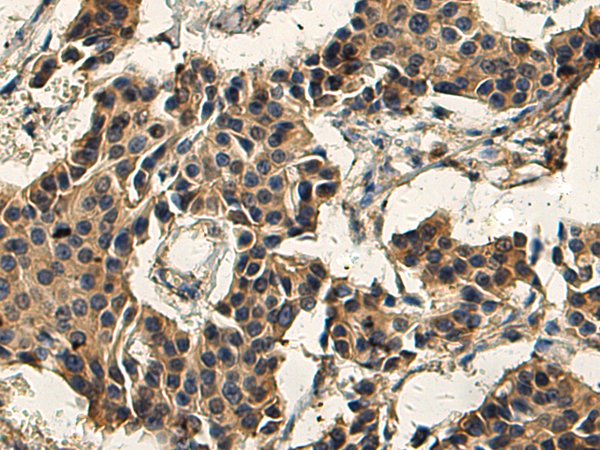

|
Background: |
This gene encodes a protein that belongs to the serine protease family. Serine proteases are known to be involved in many physiological and pathological processes. Alternative splicing results in multiple transcript variants. |
|
Applications: |
ELISA, IHC |
|
Name of antibody: |
TMPRSS5 |
|
Immunogen: |
Fusion protein of human TMPRSS5 |
|
Full name: |
transmembrane serine protease 5 |
|
Synonyms: |
SPINESIN |
|
SwissProt: |
Q9H3S3 |
|
ELISA Recommended dilution: |
5000-10000 |
|
IHC positive control: |
Human prostate cancer and Human breast cancer |
|
IHC Recommend dilution: |
200-400 |
購(gòu)物車
幫助
021-54845833/15800441009
